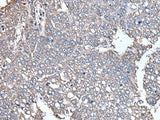
SCP2 Polyclonal Antibody Reactivity Mouse

SCP2 Polyclonal Antibody Reactivity Mouse
SKU: E-AB-52211-200
SCP2 Polyclonal Antibody Reactivity Mouse
| SKU # | E-AB-52211 |
| Reactivity | Human, Mouse, Rat |
| Host | Rabbit |
| Applications | WB, IHC |
Product Details
| Isotype | IgG |
| Host | Rabbit |
| Reactivity | Human, Mouse, Rat |
| Applications | WB, IHC |
| Clonality | Polyclonal |
| Immunogen | Fusion protein of human SCP2 |
| Abbre | SCP2 |
| Synonyms | DKFZp686C12188, DKFZp686D11188, NLTP, NSL TP, NSL-TP, Non-specific lipid-transfer protein, Nonspecific lipid transfer protein, OTTHUMP00000010488, OTTHUMP000002317, OTTHUMP00000231766, OTTHUMP00000231767, OTTHUMP00000231768, OTTHUMP00000231769, OTTHUMP00000231770 |
| Swissprot | |
| Calculated MW | 59 kDa |
| Observed MW | Refer to figures |
| Cellular Localization | Mitochondrion, Cytoplasm, Mitochondrion, Cytoplasmic in the liver and also associated with mitochondria especially in steroidogenic tissues and Peroxisome, Interaction with PEX5 is essential for peroxisomal import. |
| Concentration | 0.6 mg/mL |
| Buffer | Phosphate buffered solution, pH 7.4, containing 0.05% stabilizer and 50% glycerol. |
| Purification Method | Antigen affinity purification |
| Research Areas | Cancer, Metabolism, Signal transduction |
| Conjugation | Unconjugated |
| Storage | Store at -20°C Valid for 12 months. Avoid freeze / thaw cycles. |
| Shipping | The product is shipped with ice pack, upon receipt, store it immediately at the temperature recommended. |
Related Reagents
| Applications | Recommended Dilution |
| WB | 1:500-1:2000 |
| IHC | 1:25-1:100 |
Background
This gene encodes two proteins: sterol carrier protein X (SCPx) and sterol carrier protein 2 (SCP2), as a result of transcription initiation from 2 independently regulated promoters. The transcript initiated from the proximal promoter encodes the longer SCPx protein, and the transcript initiated from the distal promoter encodes the shorter SCP2 protein, with the 2 proteins sharing a common C-terminus. Evidence suggests that the SCPx protein is a peroxisome-associated thiolase that is involved in the oxidation of branched chain fatty acids, while the SCP2 protein is thought to be an intracellular lipid transfer protein. This gene is highly expressed in organs involved in lipid metabolism, and may play a role in Zellweger syndrome, in which cells are deficient in peroxisomes and have impaired bile acid synthesis. Alternative splicing of this gene produces multiple transcript variants, some encoding different isoforms.